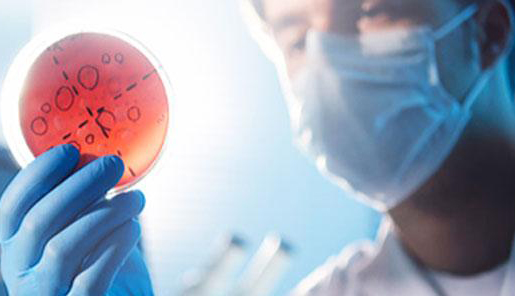
四川护理职业学院医学检验技术专业介绍

医学检验在医学行业中起着重要的作用,目前,我国对医学检验类专业人才紧缺,各个医学类相关院校也扩大该专业的招生,许多同学前来了解该专业,接下来就由成都招生教育网的老师为您详细介绍四川护理职业学院的医学检验技术专业。

四川护理职业学院是经四川省人民政府批准建立的国家公办全日制普通高等学校,是全省唯一的护理职业学院。学院现有成都、德阳两个校区,占地面积近900亩。
学院历来重视人才培养质量。培养的学生理论基础扎实、实践技能熟练、综合素养高,深受用人单位欢迎与好评,近年来就业率年均保持在95%以上。多次荣获全国职业院校技能大赛、四川省职业院校大学生护理技能大赛一、二、三等奖,使我院全方位不断提升人才培养质量。培养的学生分布在全国各地及德国、英国、新加坡等,深受国内外用人单位欢迎与好评,就业前景广阔。
专业介绍
医学检验是对取自人体的材料进行微生物学、免疫学、生物化学、遗传学、血液学、生物物理学、细胞学等方面的检验,从而为预防、诊断、治疗人体疾病和评估人体健康提供信息的一门科学。
主要课程:有机化学、无机化学、物理化学、生物化学、分子生物学、医学统计学、分析化学、检验仪器学、生理学、病理学、系统解剖学、局部解剖学、寄生虫学及检验、微生物学及检验、免疫学及检验、血液学检验、临床生物化学及检验、临床输血与检验、临床基础检验、医学英语、诊断学、内科学、外科学、妇产科学、儿科学、传染病、药理学、计算机基础与应用等。
学制及授予学位:该专业学制为四年,授予学位为理学学士。
培养目标:培养具有基础医学、临床医学、医学检验等方面的基本理论知识和基本能力,能在各级医院、血站及防疫等部门从事医学检验及医学类实验室工作的医学高级专门人才。
就业方向:该专业学生毕业后可从事临床医学检验、食品检验、卫生检验、动植物检验、医学教育和科研工作。
以上就是成都招生教育网对四川护理学院医学检验技术专业的详细介绍,希望对您了解该专业有所帮助,若想了解更多相关信息,请关注招生教育网或在线登记您的相关信息,我们的老师会尽快与您取得联系。


